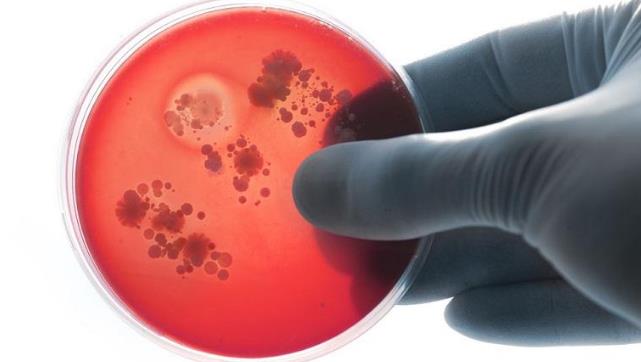
李斯特菌在冷冻中可以存活吗,李斯特菌加热10分钟能杀死吗

李斯特菌,相信大家多多少少都听说过,它是一种隐藏在冰箱中的“杀手”,尤其偏爱孕妇、儿童!大部分小伙伴可能并没有感受到李斯特菌的危害程度,那这种细菌有多可怕呢?下面就用真实案例告诉你!
•2018年1月8日,南非卫生部长莫措阿莱迪在一个新闻发布会上透露,在该国暴发的李斯特菌病(李氏杆菌病)已造成61人丧生。统计显示,这波疫情从2017年1月份开始暴发,目前已经确认至少有720人感染病毒,且成加剧状态。
•2017年11月,江苏广电融媒体新闻中心报道,扬州一名孕妇感染李斯特菌,导致新生儿早产夭折。
•2017年9月,浙江在线报道,杭州一孕妇感染李斯特菌致死胎。
•2017年8月,浙江在线报道,嘉兴二胎孕妈就因为食用了冰箱里拿出来的水果后感染李斯特菌。
•2017年8月,西部网报道,西安交大一附院新生儿科收治了三名感染李斯特菌的宝宝。
到底什么是李斯特菌?
李斯特菌又名单核球增多性李斯特菌、李氏菌,是一种兼性厌氧细菌,为李斯特菌症的病原体。李斯特菌是革兰氏阳性菌,属厚壁菌门,取名自约瑟夫·李斯特。它主要以食物为传染媒介,是最致命的食源性病原体之一。
大约一成人的消化道中自带李斯特菌,而通常摄入被李斯特菌感染的食物也不容易引发疾病,它通常只会导致机会性感染。李斯特菌一旦致病,其致死性就超过肉毒杆菌和沙门氏菌,总死亡率大约为20%~30%,被称为最致命的食源性病原体。新生儿病死率超过50%,免疫功能正常的成年人感染李斯特菌,死亡率低于10%。

它可能就藏在你家冰箱里
李斯特菌在环境中无处不在,在绝大多数食品中都能找到李斯特菌,带菌较高的食品有牛奶和乳制品、肉类(特别是牛肉)、蔬菜沙拉、海产品、冰激凌等。
李斯特菌耐冷耐盐耐酸耐碱,它还有个外号,叫“冰箱杀手”。因为它在0-45℃的环境中都可以生存,在冰箱的冷藏温度下依然可以生长繁殖,甚至在-20℃的冷冻室还能活1年。美国有一项调查发现,64%的感染李斯特菌的人,在他们家里的冰箱中都能找到这种细菌。
北京市疾病预防控制中心营养与食品卫生所副所长马晓晨介绍,李斯特菌有6种,只有单增李斯特菌对人致病,绝大多数免疫功能正常的人吃了被李斯特菌污染的食物后不会得病或只有轻微的流感样症状和胃肠道症状,很快可以自愈。但对于高危人群来说,这种病的危害很大,尤其对于孕妇来说,更应该注意。孕妇感染30%流产,新生儿感染死亡率极高!

感染李斯特菌会出现哪些症状?
李斯特菌像大肠杆菌一样,主要因食物污染传播,病从口入,经消化道感染。感染后的潜伏期较长,在一般在1周以上,最短的也要4天,平均3周。因此,很难找到是哪一种食物被李斯特菌污染造成的疫情。
李斯特菌感染人体后,首先引起发热、腹泻等胃肠炎症状,但它往往不甘心仅在肠道里安居,它最喜欢感染人的神经组织,所以常常先钻进血流,再攻入人脑,引起败血症和脑膜炎。病人主要表现为高热、意识障碍、昏迷和肢体瘫痪。有时李斯特菌还会占领心脏,导致心脏内膜发炎。它还常常感染孕妇的子宫,造成胎儿死亡和流产。有时,也可导致淋巴结炎、肝脓肿、胆囊炎、脾脓肿、关节炎、骨髓炎、脊髓炎、眼内炎等,表现多种多样。但李斯特菌病的病死率相当高,除了轻症胃肠炎患者外,脑膜炎和败血症患者的病死率大多在20%~30%,有时甚至高达47%。1983年,美国马萨诸塞州因牛乳污染导致李斯特菌病暴发,49人患病,其中14人死亡,病死率达29%。

哪些人容易感染李斯特菌?
前面说了,孕妇是感染李斯特菌的高危人群。孕妇由于细胞免疫功能下降,容易感染李斯特菌,会出现畏寒、发热、头痛、肌痛等类似上呼吸道感染症状。感染后可能会影响到胎儿,导致早产、死产或新生儿脑膜炎而死亡。
新生儿则容易在胎内感染,出生后发病。主要表现为肝、脾、肺、肾、脑等脏器内播散性脓肿或肉芽肿,还有可能出现严重的并发症如败血症及脑膜炎,甚至死亡。
根据世界各国的文献数据,孕妇如果感染单增李斯特菌,流产的比例大约在30%左右,新生儿(早产儿)的症状多为败血症、脑膜炎,死亡率高达30%-70%。2000-2009年,内地记录在案的新生儿单增李斯特菌感染25人,其中14人死亡。
另外,除了孕妇和新生儿,老年人、慢性病患者等免疫力较差人群也容易感染李斯特菌。一旦感染,轻则出现发烧、肌肉疼痛、恶心、腹泻等症状,重则出现头痛、颈部僵硬、身体失衡和痉挛等症状。
如何对付李斯特菌?
李斯特菌虽然耐冷耐盐耐酸耐碱,危害巨大,看上去很难对付。但它不耐热啊,所以消灭它其实很简单!注意卫生一定要,还有就是从冰箱里拿出来的食物要尽量热透吃!热透吃!热透吃!

1.生熟分开:一般来说,直接入口的食物要放在上面两层,比如剩饭菜、酸奶、牛奶、熟食等,而生的食物要放在下面两层,比如生蔬菜、生豆腐等。
2.孕妇、老人食品和宝宝辅食,务必进行抗菌分装,阻绝细菌降低感染风险。
3.不同位置储存不同食物:不怕冻的豆制品、奶类、剩饭菜可放得靠里些;蔬菜、水果等怕冻食品可放得靠外一些。冰箱开门的部分温度最高,适合放不易坏食品,比如奶酪、鱼干、虾皮、海米等。鲜肉、鲜鱼虾等在未冷冻时最易变质,最好放在零度冷藏保鲜盒里。
4.冰箱只放七成满:放在冰箱里的食物或容器间要留出空隙,才利于冷空气流通,确保温度达标。
5.不吃未经巴氏消毒或未煮熟的生乳及其乳制品,避免吃软奶酪。
特别需要注意的是,李斯特菌有不怕冷的特点,可以在冰箱的低温环境下繁殖,因此对家用冰箱保存的食品,存放时间不要超过3天,冰箱里存放的剩菜剩饭在食用前必须充分加热后再吃,避免吃进被李斯特菌污染的食物。

平时如何清洁冰箱?
准备工作:
1.先断电,拿出食物,清除过期、坏掉的。
2.材料准备:洗洁精、消毒酒精、醋水、牙膏、牙刷、毛巾、电吹风、筷子
冰箱外部清洗
在清洗冰箱外部的时候,可以用海绵沾水对冰箱表面的污渍进行擦拭,然后使用醋+水的混合物再擦拭一遍,冰箱表面的污渍就基本能清洗干净了。
如果冰箱的表面有油渍的话,可以使用洗洁精进行擦拭哟。
冷藏室清洗
1.果蔬盒、搁架、瓶框等,拿到水槽中清洗晾干
2.清洗内壁——湿抹布擦一遍——洗洁精水/醋水再擦一遍——干净抹布擦拭2-3遍,直到无洗洁精残留为止。
冷冻室清洗
1.先在地上铺一条吸水的布或者毛巾,防止化霜水渗到地板上;
2.用“热水+电吹风”化霜,冰霜的上面撒上一层盐,能加速冰霜融化;
3.擦拭内壁及果蔬盒、搁架等。

密封条清洗
1.先将门封条拆下来并准备好清洁剂(洗洁精/消毒酒精/1:1的醋水/食用小苏打)
2.抹布浸上清洁剂,擦拭霉点,放入加有洗洁精的温水中浸泡20分钟,清水冲洗干净,最后装回。
3.小技巧:门封条的缝不好擦,可以用牙刷哦!
凹槽清洁
冰箱的搁架、内胆、抽屉等地方有很多凹槽,用筷子顶住抹布,塞入凹槽,从前往后一捋,就擦干净啦!
去除冰箱异味
将食用小苏打放入海绵中,在冰箱内放置一天。也可以用其他的物品吸附异味,比如碳包、过期茶叶或茶渣、柠檬、橘子皮等。
清洁完毕
重新通电半小时后,即可将食物放回冰箱。

延伸阅读:
这些食物放冰箱反而“坏”的快
面包、馒头变干硬
面包、馒头、花卷、白糕等淀粉类食物,一两天内可放室温下保存,如果放入冰箱冷藏会加速食物变干变硬,这是因为一个被称为“淀粉老化回生”的过程所致,这种变化在室温下也会发生,但在冷藏温度下发生速度会更快。
香蕉、芒果怕“冻伤”
这些水果宜在12℃左右保存,放在室温阴凉处即可,过低的温度会使它们冻“伤”,发黑、腐烂。
茶叶、奶粉易发霉
这些食物本身在室温下即可保存,不需要低温保藏,放入冰箱如果密封不严,反而会使冰箱中的杂味和潮气侵入食品,既影响风味,又易发霉变质。
蜂蜜、果脯损口感
糖分高的食物本身渗透压高、水分少不宜变质,可室温下保存,放入冰箱后由于低温会促使食品结晶析出糖分,虽然这种变化不影响食品安全,但影响食物的成色和口感。巧克力放冰箱冷存后,会在表面结出一层白霜,影响口感,且易发霉变质。
青椒、黄瓜加速变质
黄瓜贮存温度为10℃至12℃,青椒为7℃至8℃,过低温度会使它们变黑、变软、变味、变质;西红柿在低温下易出现肉质呈水泡状,显得软烂,或出现散裂现象,表面出现黑斑,且无鲜味,煮不熟,甚至酸败腐烂。
本文的图片来源于网络,侵犯您的权益请联系三甲医院网删除。
本文编自网络,不代表三甲医院网观点,其中若有文字或图片侵犯您的权益请联系三甲医院网删除。
想要了解更多的看病攻略,欢迎关注“就医搜”微信公众号,每天都会有实用的文章推送给您!